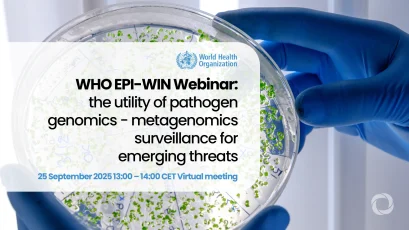
WHO EPI-WIN Webinar: the utili...

Featured Events

EU Agri-Food Days 2025

Webinar | Building Resilient Impact: How the Al-Amal Microfinance Bank Attracts Donor Partnerships in Fragile Contexts

GET Forum 2025 - Global Entrepreneurship and Technology for Latin America and the Caribbean

GET Forum brings innovation to San Salvador

EBRD Annual Meeting and Business Forum

Webinar | Insider Tips to Landing Your Dream Job at the World Bank Group

Women Leading Resilience: Cross-Regional Exchange on Inclusive Disaster Risk Reduction

From Warning to Action: Safeguarding Agricultural Livelihoods Before Disasters Strike

Papua New Guinea Investment Week 2025

Building a sustainable future for the health and wellbeing of adolescents in Central and West Africa
2,378 results
Events
Details
Sustainable & Inclusive WASH in Communities (WinC) Water, Sanitation and Hygiene (WASH) plays a key role in not only promoting health among communities but also in improving the quality of life of individuals in the target communities. WASH programmes continue to face the challenge of sustainability especially in developing countries. Sustainability mechanisms focus on ensuring that the established WASH systems continue to function optimally over ...
Event date:Aug 18, 2026
Price:350 USD
Posted:Jul 30, 2025
EBRD Annual Meeting and Business Forum The European Bank for Reconstruction and Development (EBRD) will hold its 35th Annual Meeting and Business Forum in Riga, Latvia, on 5–7 June 2026 against a backdrop of rapid change in our world.
Event date:Jun 5, 2026
Posted:Nov 17, 2025
Public Health in Emergencies (PHiE) Emergencies, such as disasters, crises, epidemics and pandemics, can all impact public health: Often people living in affected areas face disruptions to safe water and sanitation services, putting them at increased risk of waterborne and vector-borne (transmitted through an animal or insect bite) diseases.
Event date:Feb 10, 2026
Price:400 USD
Posted:Jul 17, 2025
EU Agri-Food Days 2025 The EU Agri-Food Days are the forum for stakeholders to discuss the outlook of European agriculture, agricultural market trends, food security, sustainability, digital technologies and data flows together with farmers, EU policy makers, civil society, business representatives, analysts and digital experts. This annual conference also offers the opportunity to participants to reflect on current and...
Event date:Dec 15, 2025
Location:Belgium
Price:free
Posted:Dec 2, 2025
Papua New Guinea Investment Week 2025 PNG Investment Week 2025 is Papua New Guinea's flagship global investment forum, bringing together government, industry, and international investors to unlock opportunities across the nation's most dynamic growth sectors. Hosted by PNOCORE, the event positions PNG at the centre of regional investment dialogue.
Event date:Dec 7, 2025
Location:Canada, Papua New Guinea
Posted:Nov 4, 2025
Webinar | Building Resilient Impact: How the Al-Amal Microfinance Bank Attracts Donor Partnerships in Fragile Contexts DevelopmentAid, in collaboration with the Al-Amal Microfinance Bank, invites you to attend the webinar on “Building Resilient Impact: How the Al-Amal Microfinance Bank Attracts Donor Partnerships in Fragile Contexts”
Event date:Dec 4, 2025
Price:Free
Posted:Nov 24, 2025
11th ADB International Education and Skills Forum: Applying a Fresh Lens to Unlock the Power of Human Capital ADB will host the 11th edition of its International Education and Skills Forum themed "Applying a Fresh Lens to Unlock the Power of Human Capital" on 3-5 December 2025 at its headquarters in Manila. This year’s deliberations seek to enable education systems to respond quickly to transformational trends, and to better redress persistent challenges in the education and skills development sector.
Event date:Dec 3, 2025
Posted:Aug 15, 2025
GET Forum 2025 - Global Entrepreneurship and Technology for Latin America and the Caribbean A business-oriented platform focusing on entrepreneurial innovation and technology for development.
Event date:Nov 30, 2025
Price:free
Posted:Nov 19, 2025
Arab-African Summit on Non-Profit Financing EPIK LEADERS, a visionary association dedicated to equipping young talents with the skills and tools to tackle today’s challenges and build tomorrow’s opportunities, is organizing the Arab-African Summit on Non-Profit Financing.
Event date:Nov 20, 2025
Location:Morocco
Posted:Oct 16, 2025
Webinar | Insider Tips to Landing Your Dream Job at the World Bank Group DevelopmentAid, in collaboration with the World Bank Group, invites you to attend the interactive webinar “Insider Tips to Landing Your Dream Job at the World Bank Group.”
Event date:Nov 20, 2025
Price:Free
Posted:Nov 13, 2025
Women Leading Resilience: Cross-Regional Exchange on Inclusive Disaster Risk Reduction Resilience is not gender-neutral. Research shows that gender inequality exacerbates disaster risk and impacts for women and girls. Intersectional risk factors, such as living in poverty, having a disability, living in a conflict zone, remote or rural area, can exacerbate gendered risks.
Event date:Nov 20, 2025
Price:free
Posted:Nov 12, 2025
From Warning to Action: Safeguarding Agricultural Livelihoods Before Disasters Strike Agriculture remains one of the most vulnerable sectors to disasters worldwide, with the impacts of climate change and extreme weather events threatening food security, livelihoods, and sustainable development.
Event date:Nov 18, 2025
Price:free
Posted:Nov 12, 2025
Disaster Recovery Planning and Development This course introduces fundamentals of disaster recovery principles and disaster risk reduction. During the course, we cover pre-disaster recovery planning and assessment of post-disaster recovery needs.
Event date:Nov 17, 2025
Location:Denmark
Posted:Aug 8, 2025
Building the workforce of tomorrow: inclusive participation and quality jobs for a competitive Europe Jointly organised by the European Commission and the European Economic and Social Committee (EESC), this conference will be an opportunity to take note of and discuss key insights from the two flagship reports of Directorate-General for Employment, Social Affairs and Inclusion of the European Commission (DG EMPL):
Event date:Nov 13, 2025
Location:Belgium
Posted:Sep 16, 2025
Call for Papers: Challenging Global Trade Environment and Private Sector Businesses in Asia and the Pacific ADB and the Central Asia Regional Economic Cooperation (CAREC) Institute are organizing a book project on the topic “Challenging Global Trade Environment and Private Sector Businesses in Asia and the Pacific” as part of ADB’s Asia Small and Medium-Sized Enterprise Monitor (ASM) 2025 Thematic Study. To this end, we call for related high quality unpublished papers.
Event date:Nov 13, 2025
Location:Azerbaijan
Price:free
Posted:Sep 22, 2025
25th Central Asia Media Conference “Actioning Media Viability for Informed and Resilient Societies” Marking its 25th edition, the RFoM’s Central Asia Media Conference will be held on 13 and 14 November 2025 in Tashkent, Uzbekistan. This year’s conference on “Actioning Media Viability for Informed and Resilient Societies” will spotlight how free, independent and viable media serve the public good, strengthen democratic institutions and foster social cohesion.
Event date:Nov 13, 2025
Location:Uzbekistan
Price:free
Posted:Oct 23, 2025
Webinar | Innovative Blended Finance – a key instrument in delivering high impact projects DevelopmentAid, in collaboration with Gawa Capital, Spain’s leading impact investing advisory firm, invites donor agencies, private sector organizations, foundations, NGOs, and individual experts to join the “Innovative Blended Finance – a key instrument in delivering high impact projects” webinar.
Event date:Nov 13, 2025
Location:Spain
Price:Free
Posted:Oct 30, 2025
Building a sustainable future for the health and wellbeing of adolescents in Central and West Africa
Building a sustainable future for the health and wellbeing of adolescents in Central and West Africa The third and final webinar, “Building a Sustainable Future for the Health and Wellbeing of Adolescents in Central and West Africa,” will synthesize insights from the series and foster solution-oriented dialogue among researchers, policymakers, funders and implementers. The 13 November session will focus on actionable recommendations for future programming and investment and will be available in E...
Event date:Nov 13, 2025
Posted:Nov 3, 2025
Transform Africa Summit 2025 (TAS2025) Following six successful editions, Smart Africa is organizing the seventh edition of the summit under the theme: "AI for Africa: Innovate Locally, Impact Globally", that will bring together leaders across sectors to chart an agenda for Africa’s advancement in Artificial Intelligence and other related digital domains.
Event date:Nov 12, 2025
Location:Guinea
Posted:Oct 10, 2025
Culture & Technology: Blueprints for Future-Ready Organizations | Associate Writer In November 2025, the 12th edition of the #TheCultureFactor Conference will take us on a fantastic journey to Lagos, Nigeria.
Event date:Nov 7, 2025
Location:Nigeria
Price:185
Posted:Jul 28, 2025
European Congress on Climate Change and Environmental Sustainability The European Congress on Climate Change and Environmental Sustainability will take place on November 06-07, 2025, in Vienna, Austria.
Event date:Nov 6, 2025
Location:Austria
Posted:Jun 26, 2025
Social Finance Vibe 2025: The Great Rebalancing In a world increasingly shaped by security-driven priorities and shifting global dynamics, Social Finance Vibe 2025 invites you to explore how microfinance and the social economy can adapt, innovate and lead through changes.
Event date:Nov 5, 2025
Price:Free
Posted:Oct 29, 2025
The FSD Africa Early-Stage Finance Conference The FSD Africa Early-Stage Finance Conference is the premier convening for those actively charting the future of finance in Africa. We are bringing together our pioneering Venture Finance Platform portfolio managers, strategic partners, and the wider investment ecosystem for two days of targeted engagement.
Event date:Nov 5, 2025
Location:Kenya
Posted:Oct 30, 2025
Executive Course: Decoding Migration Governance Migration remains one of today’s most pressing global challenges, often surrounded by misconceptions and political debates. This fully online course equips participants with the skills and knowledge to critically analyse migration governance at both national and international levels. Through interactive e-learning, they will develop a solid, fact-based understanding of migration dynamics, policy f...
Event date:Nov 3, 2025
Price:1286
Posted:Jul 28, 2025
Webinar | Impact Storytelling for Donor Reporting, Advocacy, and Visibility DevelopmentAid, in collaboration with Tamar Sakvarelidze, an international communications and EU project management expert, invites you to attend the interactive webinar, “Impact Storytelling for Donor Reporting, Advocacy, and Visibility”. The webinar will take place on 9 October 2025 at 3 pm (Brussels)/9 am (Washington, DC) and will offer practical insights into how storytelling can transform don...
Event date:Nov 3, 2025
Price:Free
Posted:Sep 29, 2025
Global webinar: Innovating financing for heatwave risks and urban quality of life The webinar will feature a distinguished group of speakers who will provide insights from multiple perspectives. Dr. Paolo Garonna, Professor of Political Economy at LUISS Guido Carli University of Rome and contributor to the Flames of Change report, will introduce MCR2030 and present key findings from the report.
Event date:Oct 30, 2025
Price:free
Posted:Sep 29, 2025
Webinar | Making Systems Change Work: Practical Insights from Endeva’s System Innovation Approach Join us on October 30 for an eye-opening webinar with Endeva: “Making Systems Change Work: Practical Insights from Endeva’s System Innovation Approach.” Discover how to tackle complex challenges through systemic innovation.
Event date:Oct 30, 2025
Price:Free
Posted:Oct 16, 2025
IRENA at Singapore International Energy Week (SIEW) 2025 The Singapore International Energy Week (SIEW), organised by Energy Market Authority (EMA) Singapore, is an annual platform for energy professionals, policymakers and commentators to share best practices and solutions within the global energy space.
Event date:Oct 27, 2025
Location:Singapore
Price:from 2302 USD
Posted:Oct 23, 2025
Third IATA World Sustainability Symposium The International Air Transport Association (IATA) will hold the third World Sustainability Symposium (WSS) in Hong Kong SAR, China, on 21–22 October 2025, hosted by Cathay Pacific. The event will bring together leaders from aviation, energy, finance, and policy to advance the industry’s commitment to achieving net zero CO2 emissions by 2050.
Event date:Oct 21, 2025
Location:China
Posted:Aug 21, 2025
APRA Investment Forum 2025 Following the first APRA Investment Forum, which was organised in Nairobi, Kenya in 2024 with the aim of developing and implementing a robust pipeline of energy transition projects, the second APRA Investment Forum, co-hosted by the Government of Sierra Leone and the International Renewable Energy Agency (IRENA), is scheduled to take place in Freetown, Sierra Leone, on 22-23 October 2025. The Foru...
Event date:Oct 20, 2025
Location:Sierra Leone
Posted:Sep 8, 2025
AI for ageing: Identifying older people in need of social services As populations around the world continue to age rapidly, the need for social and health support services for older people is growing. The OECD estimates that the share of the population aged 65 and over is projected to rise from 18% in 2021 to 27% by 2050 across the OECD on average, and that employment in long-term care would need to increase by 32% over the next decade to meet the expected increa...
Event date:Oct 17, 2025
Price:free
Posted:Oct 3, 2025
From Margin to Centre: Acknowledging & Strengthening Minority Women’s Role in Peacebuilding The link between violations of the rights of national minorities and the emergence or exacerbation of violent conflict has long been recognized by the international community. At the same time, frameworks like the Women, Peace and Security Agenda have highlighted women’s critical contributions to peace and security. Yet, the intersection of gender and minority identity remains still insufficiently...
Event date:Oct 15, 2025
Location:Switzerland
Price:free
Posted:Oct 7, 2025
Navigating access to innovative financial instruments for green cities and regions This workshop for city leaders and policy and finance experts will, through scene setting and focused discussions, explore how cities can leverage city networks to develop tailored financing solutions.
Event date:Oct 14, 2025
Location:Belgium
Price:free
Posted:Sep 3, 2025
Africa E-Mobility Forum 2025: Accelerating inclusive and sustainable transport in Africa Africa’s transport sector is undergoing a transformative shift toward electric mobility, driven by rapid urbanization, climate commitments, and innovative local solutions.
Event date:Oct 14, 2025
Location:Ethiopia
Posted:Sep 12, 2025
International conference of the EU-AFD Research Facility on Inequalities French Development Agency (AFD) will host the international conference of the EU-AFD Research Facility on Inequalities and its Extension, titled: “Bridging Divides: Evidence-Based Policies for Inequality Reduction and Sustainable Development.”
Event date:Oct 7, 2025
Location:France
Price:free
Posted:Jun 30, 2025
Forum on Green Finance and Investment 2025 The Forum on Green Finance and Investment is the OECD's annual flagship event on green and sustainable finance.
Event date:Oct 7, 2025
Location:France
Price:free
Posted:Sep 4, 2025
Greening Financial Systems: Peer Learning Workshop for Central Banks Building on the success of the 2024 event, the 2025 edition will further deepen peer dialogue by showcasing innovative practices and tackling real-world challenges of implementation in a rapidly evolving global context.
Event date:Oct 7, 2025
Location:Luxembourg
Posted:Sep 16, 2025
Webinar | Finnish Development Assistance: Procurement guidelines and best practices Are you a private sector entity, foundation, NGO, or individual expert interested in learning more and even starting to work with the Ministry for Foreign Affairs of Finland? Then join us for this procurement webinar to learn more about the MFA, its development cooperation objectives, and procurement framework.
Event date:Oct 2, 2025
Location:Finland
Price:Free
Posted:Sep 18, 2025
Nordic Climate Dialogues Nordic Climate Dialogues 2025, hosted in Helsinki, Finland, at Hanaholmen Cultural Centre on 1 October, brings together Nordic actors in the nexus of climate and development – high-level government representatives, financiers, strategic partners, think tanks, research institutions, and NGOs. Together with other Nordic actors, we explore ways to mobilise financing at speed and scale, bring solution...
Event date:Oct 1, 2025
Location:Finland
Price:free
Posted:Jun 20, 2025
Monitoring, Evaluation and Learning in the NGO Sector The main aim of this course is for learners to become familiar with — and develop skills for carrying out – mixed-methods monitoring and evaluation (M&E). This course will introduce key M&E concepts, methods and strategies, including theories of change, logical frameworks, indicators and measurements and preparation of research findings. We will explore participatory methods such as Action Researc...
Event date:Oct 1, 2025
Price:475 USD
Posted:Aug 11, 2025
Breaking Financing Barriers for Women in Business: the €1 billion impact 📅 30 September 2025 EBRD HQ, London Celebrating the transformational impact of the EBRD’s flagship Women in Business programme, which has mobilised over €1 billion in finance and supported more than 250,000women entrepreneurs across 23 countries. The event will bring together global partners, clients, donors and policymakers to honour a decade of achievement, reflect on…
Event date:Sep 30, 2025
Location:UK
Price:free
Posted:Aug 26, 2025
Preparedness and Response to Humanitarian Crises Current concepts, standards, principles, methods and terminology of preparedness planning and response operations are presented.
Event date:Sep 29, 2025
Location:Denmark
Price:from 2,210 EUR
Posted:Jul 30, 2025
Workshop on AI in the energy sector The use of Artificial Intelligence (AI) in the energy sector presents a significant opportunity for reduction of costs, decarbonisation and energy efficiency. The energy system is becoming more and more complex, with rising electrification, inverter-based renewables, distributed energy resources, more data available and digitalised communications and controls. Foundation models could be a powerful...
Event date:Sep 25, 2025
Posted:Sep 15, 2025
WHO EPI-WIN Webinar: the utility of pathogen genomics - metagenomics surveillance for emerging threats The International Pathogen Surveillance Network (IPSN) is a global network of pathogen genomic actors, brought together by the WHO Hub for Pandemic and Epidemic Intelligence, to accelerate progress in pathogen genomics, and improve public health decision-making. To inform country capacity building activities the webinar series aims to provide a forum for expert and evidence-based discussions on t...
Event date:Sep 25, 2025
Price:free
Posted:Sep 24, 2025
5th Asia Finance Forum: Positioning for the Future This conference aims to explore how financial systems across the region can be designed to harness the benefits of innovation and competition while enhancing financial health, promoting sustainable and green financial systems, catalyzing climate finance, fostering trust, protecting consumers, and safeguarding financial stability and resilience.
Event date:Sep 23, 2025
Posted:Jul 15, 2025
8th Vienna Energy Security Dialogue - Energy security in an era of uncertainty: navigating new realities 📅 22 September 2025 Vienna, Austria As global tensions rise and trade becomes more complex and volatile, energy security is again a top priority on the global agenda. Clean energy ambitions now intersect with geopolitical realities that are reshaping the security landscape. Against this background, the eighth edition of the Vienna Energy Security Dialogue (VESD)…
Event date:Sep 22, 2025
Location:Austria
Posted:Jul 16, 2025
For and From the Baltic: Navigating the future of fisheries with ecosystem-based management Join us for an extraordinary event hosted by ICES and the European Commission’s Directorate-General for Maritime Affairs and Fisheries (DG MARE) that will bring together the brightest minds in marine science, resource management, and policy-making to explore the future of ecosystem-based fisheries management (EBFM) in the Baltic Sea.
Event date:Sep 18, 2025
Location:Latvia
Posted:Sep 15, 2025
European Network on Gender and Violence annual conference FRA will present selected results of the EU gender-based violence survey at a conference on 17 September in Vienna. The University of Vienna and UN Office on Drugs and Crime are organising the event.
Event date:Sep 17, 2025
Location:Austria
Posted:Sep 15, 2025
European Research and Innovation Days 2025 Connecting researchers across borders and disciplines. Take part in events, access exclusive content, widen your network.
European Research and Innovation Days 2025
The European Commission’s annual flagship research and innovation event brings together policymakers, researchers, stakeholders, and the public to debate and shape the future of research and innovation in Europe and beyond.
Event date:Sep 16, 2025
Location:Belgium
Posted:Sep 15, 2025
2nd IDB Research Conference: Digital Technologies as Drivers of Growth and Well-Being in Emerging Economies This conference will explore how emerging digital technologies—such as artificial intelligence, digitalization, and automation—are reshaping the landscape of economic development. Through a series of keynote addresses, expert panels, and research presentations, participants will examine the opportunities and challenges these technologies present for productivity, labor markets, inequality, and lon...
Event date:Sep 15, 2025
Location:USA
Posted:Jul 16, 2025